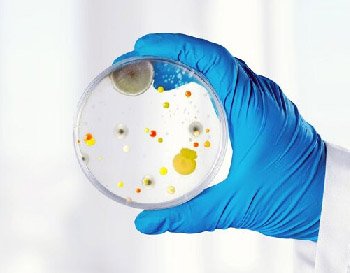

Science You Can Trust
With world-class labs and expert scientists, we provide reliable testing and research across air, water, soil, and industrial sectors. Accuracy and integrity are at the core of everything we do.

Testing Today, Protecting Tomorrow
At Chariton India, we deliver precise environmental testing solutions that safeguard communities and industries. Our science-driven approach ensures healthier ecosystems and safer living.

Advancing Research, Preserving Life
From pollution monitoring to product testing, we combine innovation with responsibility. Our mission is to protect the environment while enabling industries to thrive sustainably.

Preamble
Pollution is one of the most pressing challenges of modern civilization. Human activities have contaminated our natural environment, leading to severe effects on the ecosystem. As population and industrialization grow, so does pollution—classified broadly into Air, Water, and Soil Pollution.
Air Pollution: Release of harmful gases, particles, and biological molecules into the atmosphere, affecting all forms of life.
Water Pollution: Contamination of water bodies such as rivers, lakes, and aquifers, leading to health hazards and ecosystem damage.
Soil Pollution: Degradation of soil quality due to industrial and agricultural chemicals, resulting in poor crop yields and reduced fertility.
At Chariton Research Institute (CRI), we are committed to monitoring, testing, and offering solutions to address these environmental challenges.


About CRI
Chariton Research Institute Private Limited (CRI) is an independent research institute that was established in response to the needs of mankind and in accordance with current global requirements. CRI’s talented scientists are equipped with world-class tools in a variety of scientific domains, and the company strives to meet or exceed its customers’ expectations in terms of quality and timeliness.
Vision: To deliver cost effective and quality results in time for customer satisfaction
Mission: To improve the customer support by implementing the latest technology with sophisticated instruments on regular basis.
Featured Testing
Industries We Serve
Pharma & Biotech
Chemical Industries
IT / Software & Hardware
Manufacturing Industries
Universities & Institutions
Hospitals
Construction
Highways
Hardware
BPOs & MNCs
Testimonials

Industrial Gas Supplier
Director, Industrial Gas Supply Company
Chariton India carried out compressed air and industrial gas quality evaluations for us as per ISO standards. The entire process was smooth, transparent, and delivered with professionalism. We look forward to continuing this association.

Academic Collaboration
Dean of Science, Reputed University
Our university collaborated with Chariton Research Institute for student training in environmental monitoring and instrumentation. Their trainers were highly experienced, and our students gained valuable hands-on exposure to world-class laboratory techniques.

Healthcare Sector Client
Administrator, Multispecialty Hospital
The team at CRI supported us with food and water testing services for our hospital. Their precision and timely reporting gave us confidence in the safety standards we uphold for our patients and staff. Truly a trusted partner in healthcare compliance.

Environmental Monitoring Client
Operations Manager, Chemical Manufacturing Unit
We engaged Chariton India for air and water quality monitoring at our industrial site. Their technical staff was extremely knowledgeable and provided clear reports with actionable insights. Their service has been instrumental in helping us maintain compliance with environmental regulations.

Pharma Industry Client
Quality Head, Leading Pharma Manufacturer
Chariton Research Institute has been an invaluable partner for our pharmaceutical testing needs. Their team’s expertise in microbial and endotoxin testing helped us meet stringent compliance requirements on time. We were impressed with their accuracy, professionalism, and quick turnaround